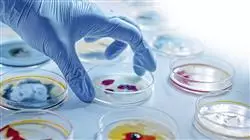
##IMAGE##

Qualificação universitária
A maior faculdade de farmácia do mundo”
Porquê estudar no TECH?
Atualize-se em apenas 6 meses sobre os principais processos para uma Gestão Financeira de Marketing Farmacêutico de sucesso"

O planejamento, a alocação e o controle eficientes dos recursos financeiros para as estratégias de marketing e promoção são fundamentais para o seu sucesso. O profissional farmacêutico com conhecimento do setor também deve levar em consideração esses fatores econômicos para poder implementar linhas de ação comercial com garantias em seu estabelecimento ou com os produtos que comercializa.
Isso envolve uma análise detalhada dos custos associados à publicidade online e offline, à participação em eventos e conferências ou à criação de materiais promocionais. Por esse motivo, foi criado o Programa avançado de Gestão Financeira do Marketing Farmacêutico, com duração de 6 meses.
Este é um Programa avançado, desenvolvido por verdadeiros especialistas que ajudarão o aluno a se aprofundar no presente da Indústria Farmacêutica, Finanças orientadas para o departamento de Marketing ou gestão de equipe dentro deste setor. Para isso, o farmacêutico receberá recursos didáticos baseados em resumos em vídeo de cada tópico, vídeos detalhados, leituras especializadas e simulações de estudos de caso.
Essa é uma excelente oportunidade para os profissionais obterem uma atualização completa nesse campo por meio de uma capacitação que se caracteriza por sua flexibilidade. Os alunos precisam apenas de um dispositivo digital (celular, tablet ou computador) com conexão à Internet para visualizar o conteúdo disponível na plataforma virtual a qualquer hora do dia.
Uma opção acadêmica que permitirá que você se mantenha atualizado com as estratégias usadas na publicidade tradicional e no Marketing Digital"
Este Programa avançado de Gestão Financeira do Marketing Farmacêutico conta com o conteúdo científico mais completo e atualizado do mercado. Suas principais características são:
- O desenvolvimento de casos práticos apresentados por especialistas em Farmácia
- O conteúdo gráfico, esquemático e eminentemente prático oferece informações científicas e práticas sobre as disciplinas que são essenciais para a prática profissional
- Exercícios práticos onde o processo de autoavaliação é realizado para melhorar a aprendizagem
- Destaque especial para as metodologias inovadoras
- Lições teóricas, perguntas a especialistas, fóruns de discussão sobre temas controversos e trabalhos de reflexão individual
- Disponibilidade de acesso a todo o conteúdo a partir de qualquer dispositivo, fixo ou portátil, com conexão à Internet
Aprimore suas habilidades em gestão financeira orientada para iniciativas de Marketing farmacêutico"
O corpo docente deste curso inclui profissionais da área que transferem a experiência do seu trabalho para esta capacitação, além de especialistas reconhecidos de sociedades científicas de referência e universidades de prestigio.
O conteúdo multimídia, desenvolvido com a mais recente tecnologia educacional, permitirá ao profissional uma aprendizagem contextualizada, ou seja, realizada através de um ambiente simulado, proporcionando uma capacitação imersiva e programada para praticar diante de situações reais.
A estrutura deste programa se concentra na Aprendizagem Baseada em Problemas, através da qual o profissional deverá tentar resolver as diferentes situações de prática profissional que surgirem ao longo do curso acadêmico. Para isso, contará com a ajuda de um inovador sistema de vídeo interativo realizado por especialistas reconhecidos.
Analise a gestão de riscos financeiros aplicada ao Marketing Farmacêutico graças a estudos de caso fornecidos por especialistas da área”

Obtenha uma visão mais aprofundada da gestão do orçamento de Marketing no conforto de sua casa”
Plano de estudos
Este Programa avançado de Gestão Financeira de Marketing Farmacêutico proporcionará aos farmacêuticos o conhecimento mais atualizado em questões orçamentárias para o marketing de produtos farmacêuticos. Dessa forma, o farmacêutico obterá insights sobre a avaliação de desempenho, a gestão de riscos monetários e a viabilidade de novos produtos. Tudo isso, sem a necessidade de investir longas horas de estudo, pois o sistema Relearning, baseado na repetição do conteúdo ajuda a reforçar os conceitos principais de uma forma mais simples.
Um plano de estudos adaptado às suas necessidades e projetado com a mais revolucionária metodologia pedagógica, o sistema Relearning"
Módulo 1. Estrutura da Indústria Farmacêutica
1.1. Desenvolvimento farmacológico
1.1.1. Descoberta de fármacos
1.1.2. Farmacocinética
1.1.3. Farmacodinâmica
1.1.4. Ensaios pré-clínicos
1.2. Laboratório Farmacêutico
1.2.1. Boas práticas de laboratório
1.2.2. Equipamentos de laboratório
1.2.3. Instrumentos de laboratório
1.2.4. Análise microbiológica
1.3. P&D
1.3.1. Técnicas de triagem
1.3.2. Técnicas de validação
1.3.3. Projeto racional
1.3.4. Química medicinal
1.4. Patentes
1.4.1. Fundamentos da propriedade intelectual
1.4.2. Procedimentos de solicitação de patentes
1.4.3. Análise de patenteabilidade
1.4.4. Estratégias de proteção
1.5. Genéricos
1.5.1. Equivalência terapêutica
1.5.2. Bioequivalência
1.5.3. Processo de desenvolvimento
1.5.4. Processo de fabricação
1.6. Gestão do estoque
1.6.1. Controle de estoque
1.6.2. Gestão de estoque
1.6.3. Métodos de previsão de demanda
1.6.4. Software Gestão do estoque
1.7. Descontos
1.7.1. Descontos por volume
1.7.2. Descontos para pagamentos imediatos
1.7.3. Descontos por fidelidade
1.7.4. Análise de lucratividade sobre descontos
1.8. Cadeia de valor do setor farmacêutico
1.8.1. Gestão de riscos
1.8.2. Tecnologias da Informação
1.8.3. Sustentabilidade
1.8.4. Responsabilidade social
1.9. Alianças estratégicas
1.9.1. Colaboradores
1.9.2. Contratos de licença
1.9.3. Joint ventures
1.9.4. Negociação de alianças estratégicas
1.10. Órgãos regulatórios
1.10.1. Vigilância pós-comercialização
1.10.2. Auditorias regulatórias
1.10.3. Harmonização regulatória
1.10.4. Reconhecimento mútuo de registros
Módulo 2. Finanças para o Departamento de Marketing
2.1. Orçamento de marketing
2.1.1. Publicidade tradicional
2.1.2. Marketing digital
2.1.3. Relações com a mídia
2.1.4. Relações públicas
2.2. Análise de custo-benefício
2.2.1. ACE
2.2.2. ACU
2.2.3. ACB
2.2.4. ACM
2.3. Medição de desempenho
2.3.1. Participação de mercado
2.3.2. Retorno do investimento
2.3.3. Pesquisa e desenvolvimento
2.3.4. Eficiência operacional
2.4. Planejamento Financeiro
2.4.1. Orçamentos
2.4.2. Gestão de estoque
2.4.3. Gestão de riscos
2.4.4. Capitalização
2.5. Gestão de risco financeiro
2.5.1. Diversificação de produtos
2.5.2. Gerenciamento da cadeia de suprimentos
2.5.3. Cobertura de riscos financeiros
2.5.4. Conclusões
2.6. Lucratividade
2.6.1. Eficiência na produção
2.6.2. Estratégias de comercialização
2.6.3. Expansão geográfica
2.6.4. Conclusões
2.7. Investimentos futuros
2.7.1. Análise de risco
2.7.2. Oportunidade de mercado
2.7.3. Escolha do momento
2.7.4. Conclusões
2.8. Os recursos financeiros da empresa
2.8.1. Capital próprio
2.8.2. Financiamento da dívida
2.8.3. Capital de risco
2.8.4. Subsídios
2.9. Retorno do Investimento
2.9.1. Patentes
2.9.2. Pesquisa
2.9.3. Análise
2.9.4. Conclusões
2.10. A viabilidade de novos produtos
2.10.1. Eficácia e segurança
2.10.2. Demanda
2.10.3. Oferta
2.10.4. Propriedade intelectual
Módulo 3. Direção e gestão de equipes na Indústria Farmacêutica
3.1. Liderança na indústria farmacêutica
3.1.1. Tendências e desafios da liderança
3.1.2. Liderança transformacional
3.1.3. Liderança na gestão de riscos
3.1.4. Liderança em melhoria contínua
3.2. Gestão de talentos
3.2.1. Estratégias de recrutamento
3.2.2. Desenvolvimento de perfis
3.2.3. Planejamento de sucessão
3.2.4. Retenção de talentos
3.3. Desenvolvimento e capacitação da equipe
3.3.1. Boas Práticas de Fabricação (BPF)
3.3.2. Desenvolvimento de habilidades técnicas
3.3.3. Capacitação em segurança
3.3.4. Desenvolvimento de P&D
3.4. Estratégias de comunicação interna
3.4.1. Desenvolvimento de uma cultura de comunicação aberta
3.4.2. Comunicação de objetivos e estratégias
3.4.3. Comunicação de mudanças organizacionais
3.4.4. Comunicação de políticas e procedimentos
3.5. Gestão de desempenho
3.5.1. Definição de metas e objetivos claros
3.5.2. Definição de indicadores de desempenho
3.5.3. Feedback contínuo
3.5.4. Avaliação de desempenho
3.6. Gestão de mudanças
3.6.1. Diagnóstico da necessidade de mudança
3.6.2. Comunicação efetiva da mudança
3.6.3. Criação de um senso de urgência
3.6.4. Identificação de líderes de mudança
3.7. Gestão de qualidade
3.7.1. Definição de padrões de qualidade
3.7.2. Implementação de sistemas de gestão de qualidade
3.7.3. Controle de qualidade na produção
3.7.4. Gestão de provedores
3.8. Gerenciamento do orçamento de Marketing
3.8.1. Planejamento estratégico de Marketing
3.8.2. Estabelecimento do orçamento total de Marketing
3.8.3. Distribuição do orçamento por canais de Marketing
3.8.4. Análise do retorno do investimento (ROI)
3.9. Planejamento e execução de campanhas de marketing
3.9.1. Análise do mercado e do público-alvo
3.9.2. Definição dos objetivos da campanha
3.9.3. Desenvolvimento de estratégias de Marketing
3.9.4. Seleção de canais de marketing
3.10. Atualização de notícias do mercado
3.10.1. Análise das tendências de mercado
3.10.2. Monitoramento da concorrência
3.10.3. Acompanhamento dos avanços no setor
3.10.4. Participação em eventos e conferências

Com a TECH, você estará atualizado sobre as técnicas e ferramentas utilizadas no planejamento e na execução de campanhas de Marketing Farmacêutico"
Programa Avançado de Gestão Financeira do Marketing Farmacêutico
O Programa Avançado de Gestão Financeira do Marketing Farmacêutico da TECH Universidade Tecnológica é um programa acadêmico de alto nível destinado a profissionais do setor farmacêutico que desejam expandir seus conhecimentos na área financeira de marketing, especificamente na gestão financeira de produtos farmacêuticos. Estes estudos permitem que os participantes adquiram habilidades e ferramentas essenciais para a análise financeira no setor farmacêutico, bem como para a tomada de decisões importantes em investimentos publicitários focados neste mercado. Para isso, são fornecidos conhecimentos em finanças, contabilidade e análise de dados financeiros. O Programa Avançado de Gestão Financeira do Marketing Farmacêutico é realizado na modalidade online, permitindo que os alunos acessem os conteúdos e materiais de estudo de qualquer lugar e a qualquer momento, ajustando assim seu tempo de trabalho às suas necessidades particulares. Além disso, o programa é projetado para que a participação e a aprendizagem sejam dinâmicas, colaborativas e interativas.
Estude e enriqueça seu currículo
O principal objetivo deste programa é capacitar especialistas na tomada de decisões financeiras no campo do marketing farmacêutico. Ao concluir o programa os alunos terão adquirido as habilidades e ferramentas necessárias para analisar e avaliar os custos e benefícios de investimentos publicitários para produtos e serviços na área da saúde, considerando aspectos legais e regulatórios. Em resumo, o Programa Avançado de Gestão Financeira do Marketing Farmacêutico é o programa acadêmico ideal para aqueles que buscam se especializar e se destacar na área financeira do marketing no setor farmacêutico. Seus conteúdos, metodologia e modalidade online o tornam uma excelente opção de formação para qualquer pessoa que deseje desenvolver sua carreira neste campo. Não pense mais e capacite-se com a TECH.







